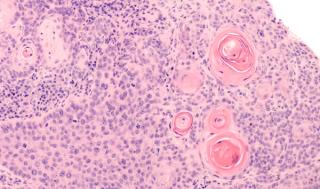
Deep Dive Into High-Risk Cutaneous Squamous Cell Carcinoma

Non-Melanoma Skin Cancers
Latest News
Latest Videos

CME Content
More News

Catch up on the innovative pearls shared at the 2023 American College of Mohs Surgery including strategies to enhace the patient experience, the role artificial intelligence plays in dermatologic care, and more.

Brandon Beal, MD shared his experience, which technology solutions work best, and resources available to dermatology practices.

The rapid pearl session explored a case that challenged surgeons to preserve the function of the tarsal plate and musculature attachments.

His keynote speech at ACMS focused on artificial intelligence for precision medicine and cancer diagnosis.

Jerry Brewer, MD, MS, shared pearls on reasons to avoid or discontinue Mohs surgery and keeping calm with stressed, vulnerable patients.

Katie Schlenker, DO, emphasizes the importance of empathy during tough conversations with skin cancer patients with few to no treatment options left.

Golda explains why he prefers using tranexamic acid to control bleeding in granulated wounds.

An ACMS poster session indicates Mohs micrographic surgeons and histology technicians are at high risk of developing musculoskeletal injuries from their day-to-day tasks.

Laura Rezac, MD and her colleagues evaluated a teledermatology postoperative follow-up model after Mohs Micrographic surgery.

Caleb Kovell, MD and Junqian Zhang, MD demonstrated how teaming up increases the likelihood for positive patient outcomes in Mohs cases on the genitalia and perianal region.

The question was a conversation starter after an ACMS clinical abstract presentation.

An ACMS poster session delves into the role artificial intelligence can play in the treatment of basal cell carcinoma.

A poster session and ACMS keynote speaker Anant Madabhushi, MS, PhD, both delve into the use of AI in Mohs surgery.

Bar will share insight on foldover interpolated flaps for full thickness of nasal defects.

From explaining how medications work and should be taken to reviewing potential adverse effects and financial details, pharmacists are crucial resources for patients undergoing treatment for skin cancer.

The task force defined screening as a visual skin exam by a primary care clinician for this recommendation.

Verrica Pharmaceuticals is developing a potentially first-in-class oncolytic peptide.

With the advent of immunotherapy, the 1-year survival rate for patients with metastatic melanoma has increased from 25% to 50%.

Incyte’s MCC indication is approved under accelerated approval based on tumor response rate and duration of response.

The commander-in-chief’s cancerous tissue was successfully removed last month.

Transplant patients are at a higher risk of nonmelanoma carcinomas due to immunosuppressive therapies.

In this week’s Pointers with Dr Portela, the 208SkinDoc discusses basal cell carcinoma and Mohs surgery related to Jill Biden's most recent skin cancer diagnosis.

Merkel cell carcinoma is a rare but highly aggressive type of nonmelanoma skin cancer and Merkel cell polyomavirus is thought to play a major role in its etiology.

This review will explore various leukemia-related cutaneous findings and discuss the diagnosis and management of these conditions.

Darrell S. Rigel shares current updates in skin cancer treatments and incidences across the US at Winter Clinical Hawaii.